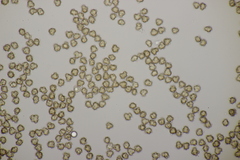
Tomentella punicea
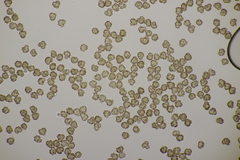
Tomentella punicea

Tomentella punicea: taxon details and analytics
- Domain
- Kingdom
- Fungi
- Phylum
- Basidiomycota
- Class
- Agaricomycetes
- Order
- Thelephorales
- Family
- Thelephoraceae
- Genus
- Tomentella
- Species
- Tomentella punicea
- Scientific Name
- Tomentella punicea
Tomentella punicea in languages:
- Czech
- vatička granátová
- Czech
- vatička hnědočervená
- Dutch
- Bont rouwkorstje
- Finnish
- mustakahvikka
- Hungarian
- vörös nemezgomba
Images from inaturalist.org observations:
We recommend you sign up for this excellent, free service.
Parent Taxon
Sibling Taxa
- Hypochnus eylesii
- Tomentella asperula
- Tomentella atroarenicolor
- Tomentella badia
- Tomentella bicolor
- Tomentella brevispina
- Tomentella bryophila
- Tomentella cinerascens
- Tomentella cinereoumbrina
- Tomentella clavigera
- Tomentella coerulea
- Tomentella crinalis
- Tomentella ellisii
- Tomentella epiphylla
- Tomentella ferruginea
- Tomentella ferruginosa
- Tomentella fuscocinerea
- Tomentella fuscoferruginosa
- Tomentella galzinii
- Tomentella guineensis
- Tomentella guinkoi
- Tomentella italica
- Tomentella lapida
- Tomentella lateritia
- Tomentella lilacinogrisea
- Tomentella muricata
- Tomentella neobourdotii
- Tomentella nitellina
- Tomentella oligofibula
- Tomentella pilosa
- Tomentella pulvinulata
- Tomentella punicea
- Tomentella radiosa
- Tomentella scobinella
- Tomentella stuposa
- Tomentella subclavigera
- Tomentella sublilacina
- Tomentella subtestacea
- Tomentella subvinosa
- Tomentella terrestris
- Tomentella testaceogilva
- Tomentella umbrinospora
- Tomentella viridula